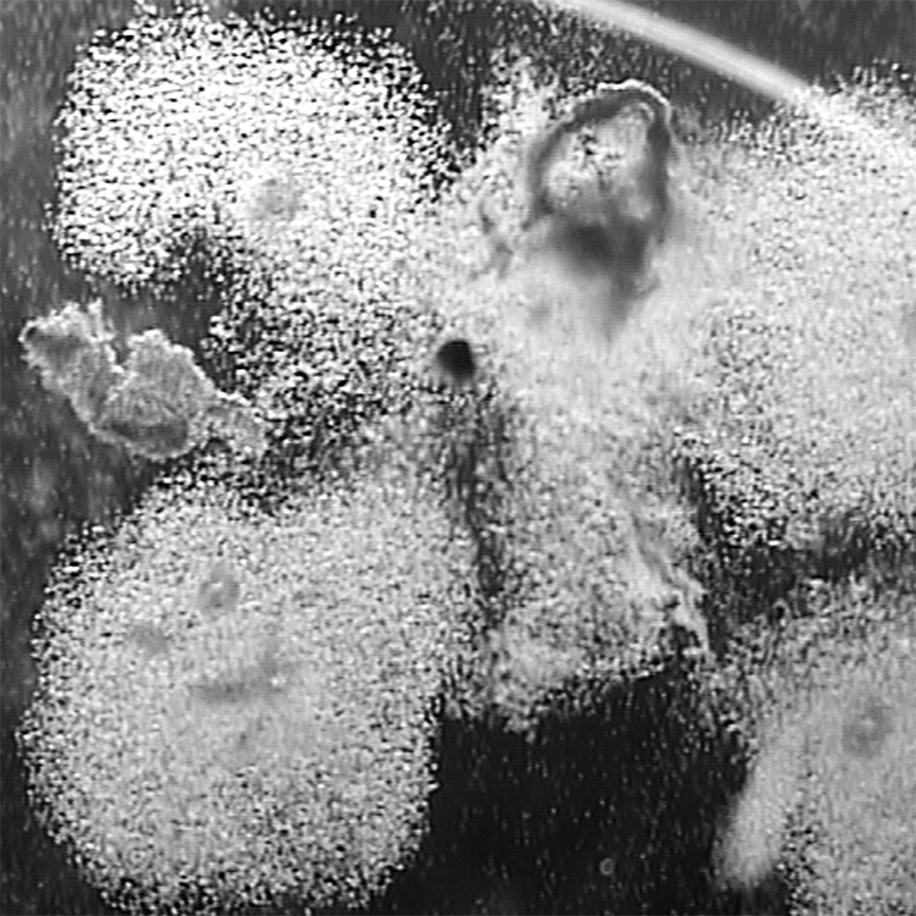

SEED is about the experience of having IVF and the current cultural context for the treatment. Worldwide, 1in 6 couples struggle to become parents. The success rate of IVF varies from 32.2 percent to 1.9 percent depending on the age of the woman (this affects the amount of eggs a woman has) and the cause of infertility. For one in three couples, the issue is male infertility.
The project aims to increase awareness and understanding of fertility treatment.
The couples who took part in SEED reflect a range of fertility diagnoses and the associated treatments that are now available – from IVF (In vitro fertilisation) and ICSI (Intracytoplasmic Sperm Injection) to couples using donor sperm and Pre Genetic Diagnosis as part of their treatment.
One in four couples become pregnant from their first cycle of IVF. In this project, out of the sixteen couples that took part, five had a baby from their first cycle. Two couples went on to have a baby from a Frozen Embryo Transfer and one couple from their second treatment cycle.
The project has been facilitated by the Fertility Clinic at Life, Newcastle upon Tyne; funded by the Arts Council and supported by the North East Photography Network.
The project aims to increase awareness and understanding of fertility treatment.
The couples who took part in SEED reflect a range of fertility diagnoses and the associated treatments that are now available – from IVF (In vitro fertilisation) and ICSI (Intracytoplasmic Sperm Injection) to couples using donor sperm and Pre Genetic Diagnosis as part of their treatment.
One in four couples become pregnant from their first cycle of IVF. In this project, out of the sixteen couples that took part, five had a baby from their first cycle. Two couples went on to have a baby from a Frozen Embryo Transfer and one couple from their second treatment cycle.
The project has been facilitated by the Fertility Clinic at Life, Newcastle upon Tyne; funded by the Arts Council and supported by the North East Photography Network.